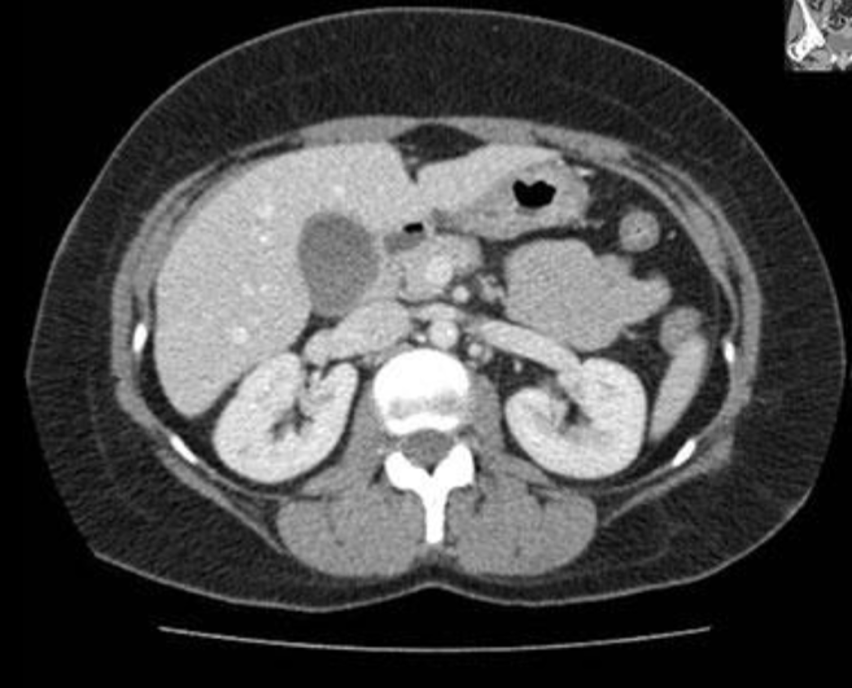

Systematisk gennemgang af CT:
- Patientidentifikation:
1) Modalitet og skanningsområde: fx CT thorax og abdomen
2) Kontrastfase: med/uden kontrast (i.v. eller p.o.), én eller flere faser (tom/arteriel/venøs)
3) Plan: aksial (transversal) / coronal (frontalt) / sagittal (longitudinal)
4) Skanningsvindue: bløddelsvindue / lungevindue / knoglevindue / anden - Systematisk gennemgang af organer/strukturer
- Konklusion / Diagnose
Kontrastfaser:
- De fleste CT-skanninger er venøse. CTC bruger dog tom-skanning pga. blødningsmistanke
- Aorta og nyrernes kontrastopladning kan bruges til at skelne mellem de forskellige kontrastfaser
- Tom-kontrastfase: 1
- Arteriel-kontrastfase: 2
- Venøse-kontrastfase: 3

1: ingen kontrast (fx CTC)
2: tydelig lys aorta
3: mere ensartede (lyse) nyrer

Skanningsorientering – Planer:
- Aksial (transversal): op/ned
- Coronal (frontalt): for/bag
- Sagittal (longitudinal): højre/venstre

Skanningsvindue:
- De fleste CT-skanninger er i bløddelsvindue
- Bløddelsvindue: altid
- Lungevindue: ved thorax
- Knoglevindue: ved traume / mistanke om knoglepatologi

Nævn basale organer på CT:

Nævn basale organer på CT:


Akut appendicitis:

Diagnose?

Akut appendicitis
Infarkt (apopleksi/TCI):

Diagnose?

Infarkt (apopleksi/TCI)
Hjerneblødning:

Diagnose?

Subarachnoidalblødning (SAH)
Diagnose?

Intracerebral hæmoragi (ICH)
Lungeemboli:
- Embolier (mørke) omsluttet af blod (lyst)

Diagnose?

Lungeemboli
Diagnose?

Lungeemboli
Hydronefrose:

Diagnose?

Hydronefrose
Miltraume:

Miltraume:

Diagnose?

Miltraume
Perforeret ulcus:

Perforeret ulcus:

Diagnose?

Perforeret ulcus
Lungecancer:

Diagnose?

Lungecancer






